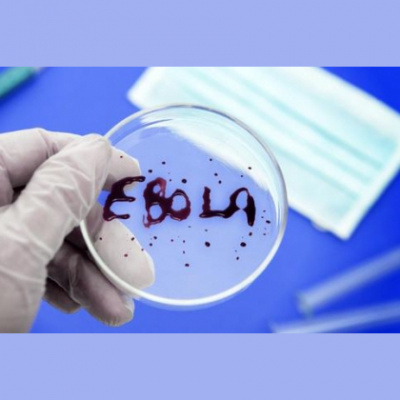
Septias Dienas Eirop

Septias Dienas Eirop
Gada aktualitātes - kaimiņattiecības, ebolas vīruss un politiskie procesi Eiropā
- Autor: Vários
- Narrador: Vários
- Editor: Podcast
- Duración: 0:44:55
- Mas informaciones
Informações:
Sinopsis
Raidījumā atskatamies uz tiem 2014. gada notikumiem pasaulē un Eiropā, spriežam, kā šie notikumi ietekmēs norises nākamajā gadā, kā ietekmēs mūs tepat Latvijā. Viesi studijā: vēsturnieks Gustavs Strenga, filozofs Ilmārs Šlāpins un žurnālists Filips Lastovskis. Diskutējam par šādiem tematiem: Ukrainas konflikts un sankciju spēles – Krievijas agresija kā ievads jaunam Aukstam karam; Eiropas cietoksnis – kā migranti un ebola grabina pie Eiropas Savienība ārdurvīm un dažas valstis grib slēgt namdurvis pat tuvākiem kaimiņiem; Kāpēc Eiropas Savienība nespēj uzrunāt vēlētājus? Ko varam secināt pēc Eiropas Parlamenta vēlēšanām un Eiropas Komisijas izveides procesa. Žurnāls “Foreign Policy” ir nodēvējis aizgājušo gadu kā planētas “karstāko” gadu gan temperatūras, gan notikumu ziņā. Kā pamatojumu šis žurnāls min tādus notikumus, kā revanšistu organizēto Krimas aneksiju, prokrievisko separātistu uzkurināšanu un uzturēšanu Eiropas austrumu perifērijā, tiek pieminēta islāma valsts izniršana it kā no nekurienes un viņu